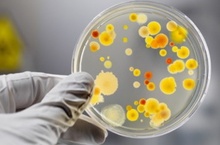

Муниципальное казенное учреждение «Управление образования» ИКМО "Лениногорский муниципальный район" Республики Татарстан Татарстан Республикасы “Лениногорск муниципаль районы” муниципаль берәмлеге “Мәгариф идарәсе” муниципаль учреждениесе
Визитная карточка
| Адрес: | 423250, Республика Татарстан, Лениногорский район, г. Лениногорск, ул. Шашина, д. 22 |
| Телефон: | +7(855)-955-12-22 |
| E-Mail: | Imc.Len@tatar.ru |
| Министерство: | Министерство образования и науки Республики Татарстан |
| Короткое название: | МКУ "Управление образования" ИКМО "ЛМР" РТ |
| Руководитель: | Санатуллин Вагиз Самиуллович |
| Год основания учреждения: | 2006 |
Муниципальное казенное учреждение «Управление образования» ИКМО "Лениногорский муниципальный район" Республики Татарстан Татарстан Республикасы “Лениногорск муниципаль районы” муниципаль берәмлеге “Мәгариф идарәсе” муниципаль учреждениесе - новости
Страницы: << 191 192 193 194 ( 195 ) 196 197 198 199 200 >>
-
Внимание: энтеровирусная инфекция! 05.07.2013
Управление Роспотребнадзора по Республике Татарстан (Татарстан) информирует, что в ряде территорий Российской Федерации в настоящее время сложилась неблагоприятная эпидемиологическая ситуация по энтеровирусной инфекции.
-
Международный день борьбы со злоупотреблением наркотических средств и их незаконного оборота 27.06.2013

С целью формирования у детей представления о негативном воздействии наркотических веществ на здоровье человека, воспитания у школьников отрицательного отношения к наркотическим веществам, а также с целью освоения норм поведения, которые помогут избежать пагубной привычки, в 33 пришкольных лагерях дневного пребывания 26 июня 2013г. были проведены мероприятия, посвященные Международному дню борьбы с наркоманией.
-
Акция «Помоги своей школе!» 19.06.2013

13 июня в Татарстане стартовала акция «Помоги своей школе!», инициированная Президентом Республики Татарстан Рустамом Миннихановым. Организаторами акции выступили Министерство образования и науки РТ совместно с Министерством строительства, архитектуры и ЖКХ РТ и Республиканским агентством по печати и массовым коммуникациям.
Главная задача каждой школы - воспитать успешного выпускника. Успехами своих воспитанников гордятся учителя, о них рассказывают нынешним ученикам.
Многие выпускники, при всей своей занятости, находят время и помогают своей родной школе. -
Поздравляем команду МАОУ «Средняя общеобразовательная школа №2» города Лениногорска «Грамотеи» 14.06.2013

Поздравляем команду МАОУ «Средняя общеобразовательная школа №2» города Лениногорска «Грамотеи» и их руководителя учителя русского языка и литературы Зелепугину Галину Петровну, занявшую 2 место на I Всероссийском молодежном образовательном фестивале русского языка и литературы «Язык. Культура. Творчество», посвященного празднованию Дня русского языка и Пушкинского дня Росси, проходившего в с 3 по 7 июня в городе Санкт-Петербурге.
-
Проведение “Дня русского языка” в Лениногорском муниципальном районе 06.06.2013

6 июня в день рождения великого русского поэта, основоположника современного русского литературного языка Александра Сергеевича Пушкина в России и в мире отмечается День русского языка.
-
1 июня казанский ИТ-парк встретил первых ИТ-Чемпионов 03.06.2013

1 июня в День защиты детей в казанском ИТ-парке состоялась первая торжественная церемония награждения ИТ-Чемпионов – победителей I этапа республиканского конкурса среди школьников в номинации «Самый активный школьник», организованного Министерством информатизации и связи РТ и Министерством образования и науки РТ.
-
Пятидневные учебные сборы 31.05.2013

В период с 27 мая по 31 мая 2013 года на базе стадиона спортивного комплекса “Юность” и МБОУ «Шугуровская СОШ им. В.П. Чкалова» состоялись пятидневные учебные сборы с учащимися 10-х классов образовательных учреждений. Всего в учебных сборах приняли участие 147 юношей, из них: 10 учащихся - на базе МБОУ «Шугуровская СОШ им. В.П. Чкалова», 137 юношей – на базе стадиона спортивного комплекса “Юность”.
-
Торжественная церемония награждения победителей первого этапа Республиканского конкурса «IТ-Чемпион» 30.05.2013

1 июня 2013 года в Казани в ИТ-парке состоится торжественное награждение победителей первого этапа Республиканского конкурса «IТ-Чемпион» среди учащихся общеобразовательных учреждений Республики Татарстан в номинации «Самый активный учащийся».
-
«Марш Парков – 2013» 28.05.2013

22 мая 2013 года в МАОУ «СОШ№2» прошло общешкольное мероприятие, посвященное подведению итогов природоохранной Международной акции «Марш Парков – 2013». В акции приняли участие 220 учащихся.
-
Финал Республиканского конкурса среди отрядов профилактики правонарушений образовательных учреждений Татарстана 22.05.2013

В Республиканском детском оздоровительно-образовательном центре «Костер» 16 -18 мая состоялся финал Республиканского конкурса среди отрядов профилактики правонарушений образовательных учреждений Татарстана, который проводится по инициативе Кабинета Министров Республики Татарстан.Организаторами конкурса выступают Министерство внутренних дел по РТ, Министерство образования и науки Республики Татарстан, Министерство по делам молодежи, спорту и туризму Республики Татарстан.

















